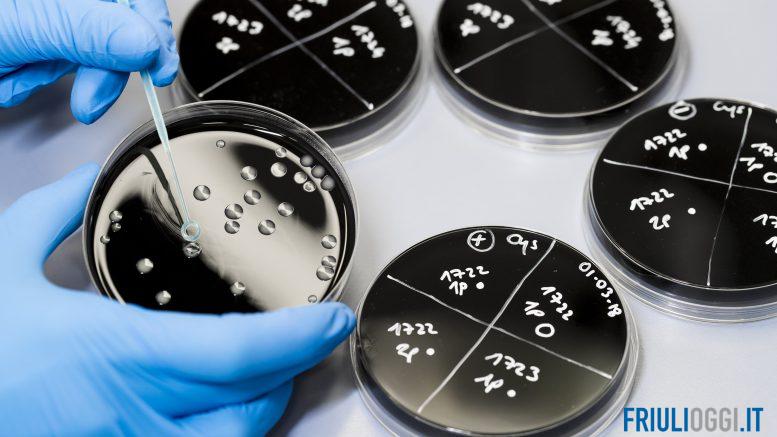

Il nuovo impianto di disinfezione dell’acqua potabile.
A partire da domenica 12 gennaio 2025, CAFC S.p.A. avvierà il nuovo impianto di disinfezione dell’acqua potabile presso la centrale di Musi, nel Comune di Lusevera. Il nuovo sistema, basato sull’utilizzo di biossido di cloro (ClO₂), sostituirà l’attuale impianto che utilizza ipoclorito di sodio per la disinfezione.
Il biossido di cloro, scelto per la sua efficacia come agente battericida, garantisce una durata d’azione in acqua di almeno 48 ore, migliorando così la sicurezza della risorsa idrica. Il nuovo impianto fornirà tratterà l’acqua potabile distribuita ai Comuni di Buja, Lusevera, Magnano in Riviera, Nimis e Tarcento.
Possibili alterazioni dell’acqua durante la transizione
Durante la fase di avviamento, gli utenti potrebbero riscontrare lievi alterazioni organolettiche dell’acqua, dovute sia all’introduzione del nuovo agente disinfettante, sia al necessario periodo di stabilizzazione della rete idrica. Il biossido di cloro, infatti, ha un potere ossidante più elevato rispetto all’ipoclorito di sodio, e verrà inizialmente dosato a concentrazioni percepibili a livello olfattivo.
CAFC S.p.A. ha pianificato una serie di misure per ridurre al minimo i disagi. Verranno effettuati controlli regolari lungo la rete di distribuzione per monitorare la concentrazione di biossido di cloro e il suo decadimento, a partire dal punto di immissione fino ai punti finali. Inoltre, è previsto un piano di lavaggi della rete.
Tale fase si protrarrà a partire dal 13 gennaio 2025 per la durata di tutta la settimana e conseguentemente si procederà ad una graduale diminuzione della concentrazione di biossido immessa in rete garantendo la qualità della risorsa idrica. Cafc precisa che per tutta la durata del periodo transitorio di sostituzione del sistema di disinfezione, l’acqua continuerà a mantenere le caratteristiche di potabilità.
Nella prima fase di impiego del nuovo sistema di disinfezione a base di biossido di cloro potrebbero verificarsi alcune irregolarità temporanee nella fornitura dell’acqua, alterazione del colore e dell’odore (percepito in modo più intenso con l’acqua calda), dovute al cambio di disinfettante nella rete pubblica e privata, di cui resta comunque confermata la potabilità dal punto di vista chimico e batteriologico.
Questo intervento va a migliorare la qualità dell’acqua erogata e controllata grazie a un metodo di disinfezione di altissima reattività ed efficienza. Il biossido ha una azione estremamente ampia non solo sui batteri, ma anche su virus, alghe ed altri componenti biologici. È più efficiente nell’abbattimento della legionella. Migliore garanzia di sanificazione.
Sul sito web cafcspa.com è possibile consultare i risultati delle analisi eseguite sull’acqua che arriva ai rubinetti di ogni comune servito accedendo al menù “L’Acqua di CAFC – Analisi dell’acqua”, dove è possibile prendere visione delle analisi relative all’opera di presa da cui deriva l’acqua servita nel comune e nella via selezionata e dell’analisi eseguita presso il punto di prelievo locale.
Ecco i Comuni e le frazioni interessate dal nuovo impianto di disinfezione: